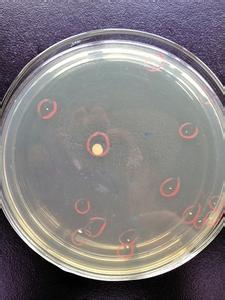

洁净室综合性能检测项目
●风速 ●自净时间
●风量(换气次数) ●密闭性检测
●温度和相对湿度 ●高效过滤器检漏
●悬浮粒子数 ●臭氧浓度
●浮游菌 ●紫外强度
●沉降菌 ●空气中细菌菌落总数
●静压差 ●工作台表面细菌菌落总数
●照度 ●工人手表面细菌菌落总数
●噪声 ●静电
●气流流型
1、温度和相对湿度:
 空调系统已经运转,各项状况已经稳定。每个控温区至少设置一个温度测点,测点设在制定位置的工作高度,待显示稳定后,记录个测点的温度读数,测量时间不少于5min,每分钟至少记录1个读数。
空调系统已经运转,各项状况已经稳定。每个控温区至少设置一个温度测点,测点设在制定位置的工作高度,待显示稳定后,记录个测点的温度读数,测量时间不少于5min,每分钟至少记录1个读数。
2、风速测量:

对于单向流洁净室,取离高效过滤器0.3m 垂直于气流处的截面作为采样截面,截面上测点间距不宜大于0.6m,测点数不应少于5点,所有读数的算术平均值作为平均风速。
3、风量:
 测试时,风量罩应将整个风口罩牢,风量罩的四边与风口的四周贴住,待屏幕显示值相对稳定后读数、记录。每一点的测试时间不应少于10s,每个测试位置的测点数不应少于3点。全部风口的风量之和即为总风量。
测试时,风量罩应将整个风口罩牢,风量罩的四边与风口的四周贴住,待屏幕显示值相对稳定后读数、记录。每一点的测试时间不应少于10s,每个测试位置的测点数不应少于3点。全部风口的风量之和即为总风量。
换气次数
换气次数=洁净室总风量÷洁净室容积
4、静压差
 静压差的测定应在所有的门关闭时进行,有排风时,应在最大排风量条件下进行,并宜从平面上最里面的房间依次向外测定相邻相通房间的压差,直至测出洁净区与非洁净区、室外环境之间的压差。
静压差的测定应在所有的门关闭时进行,有排风时,应在最大排风量条件下进行,并宜从平面上最里面的房间依次向外测定相邻相通房间的压差,直至测出洁净区与非洁净区、室外环境之间的压差。
5、悬浮粒子
 对任何小洁净室或局部空气净化区域
对任何小洁净室或局部空气净化区域
采样点的数目不得少于2个,总采样次数不得不于5次。
可按下公式计算。 NL=A0.5
采样布点:
a.采样点一般在离地面0.8m高度的水平面上均匀布置;
b.布置采样点时,应避开回风口。
6、浮游菌
 最少采样点数目对上面悬浮粒子采样点数。工作区测点位置离地0.8m~1.5m左右(略高于工作面);送风口测点位置离开送风面30cm左右;关键设备或关键工作活动范围处可增加测点。每个采样点一般采样一次。
最少采样点数目对上面悬浮粒子采样点数。工作区测点位置离地0.8m~1.5m左右(略高于工作面);送风口测点位置离开送风面30cm左右;关键设备或关键工作活动范围处可增加测点。每个采样点一般采样一次。
a.全部采样结束后,将培养皿倒置于恒温培养箱中培养;
b.在30℃~35℃培养箱中培养,时间不少于48h;
c.每批培养基应有对照试验,检验培养基本身是否污染。可每批选定3只培养皿作对照培养。
7、沉降菌
 工作区采样点的位置略高于工作面;将已制备好的培养皿置于采样点,打开培养皿盖,使培养基表面暴露0.5h,再将培养皿盖盖上后倒置。培养条件同浮游菌。
工作区采样点的位置略高于工作面;将已制备好的培养皿置于采样点,打开培养皿盖,使培养基表面暴露0.5h,再将培养皿盖盖上后倒置。培养条件同浮游菌。
8、噪声
 测点距地面高1.1m。洁净室面积在15m2以下者,可只测室中心1点;面积在15m2以上,除测室中心1点外,应再测对角4点,距侧墙各1m,测点朝向各角;测点高度距地面1.1m。
测点距地面高1.1m。洁净室面积在15m2以下者,可只测室中心1点;面积在15m2以上,除测室中心1点外,应再测对角4点,距侧墙各1m,测点朝向各角;测点高度距地面1.1m。
9、照度
 测点平面离地面0.8m,按1m~2m间距布置,30m2以内的房间测点距墙面0.5m,超过30m2的房间测点距离墙面1m。
测点平面离地面0.8m,按1m~2m间距布置,30m2以内的房间测点距墙面0.5m,超过30m2的房间测点距离墙面1m。
10、自净时间
 (1)提升起始浓度,以达到或超过100倍目标.具体做法是:关闭空调净化系统,用巴兰香烟发烟2min-3min,开启粒子计数器进行监测,粒子计数确认0.5um粒子浓度已超过目标浓度的100倍,注意粒子浓度达到100×目标浓度时的时间t100n。
(1)提升起始浓度,以达到或超过100倍目标.具体做法是:关闭空调净化系统,用巴兰香烟发烟2min-3min,开启粒子计数器进行监测,粒子计数确认0.5um粒子浓度已超过目标浓度的100倍,注意粒子浓度达到100×目标浓度时的时间t100n。
(2)开启净化系统,开始测量的最小间隔为1分钟,注意粒子浓度达到目标浓度时的时间(tn)。
(3)计算自净时间
100:1自净时间为t0.01=(tn–t100n)。
11、密闭性检漏
 密闭性检测是测定洁净室(区)有无受污染的空气从周围具有相同或不相同静压的较低洁净度等级的洁净室(区)或非洁净室(区)侵入。
密闭性检测是测定洁净室(区)有无受污染的空气从周围具有相同或不相同静压的较低洁净度等级的洁净室(区)或非洁净室(区)侵入。
1、采用粒子计数器法检测洁净室(区)的密闭性,检测时应先测量紧靠被测围护结构表面外部的悬浮粒子浓度,一般此浓度应比洁净室(区)内浓度大103,并大于等于3.5×106个/m3待测粒径的粒子。
2、洁净室(区)的施工接缝,包括对墙板、吊顶的接缝和管线、灯具等的接缝的渗漏检测,应在被测部位的50mm~100mm处扫描,其扫描速度为50mm/s。
12、气流流型
 气流流型检测是确定室内设备、设施对气流的影响,选择或改善气流流型使之产生最小的湍流和最大的清除能力。
气流流型检测是确定室内设备、设施对气流的影响,选择或改善气流流型使之产生最小的湍流和最大的清除能力。
1、测点布置:
垂直单向流洁净室选择纵、横剖面各一个,以及距地面高度0.8m、1.5m的水平面各一个;水平单向流洁净室选择纵剖面和工作区高度水平面各一个。
乱流洁净室选择通过代表性送风口中心的纵、横剖面和工作区高度的水平面各1个。
2、测试操作:
 在各个测点用雾化器根据布点位置进行发烟,在被测平面上移动发烟器,测试者目视观察随气流运动的烟雾变化情况。并用数码设备摄像记录测试情况。
在各个测点用雾化器根据布点位置进行发烟,在被测平面上移动发烟器,测试者目视观察随气流运动的烟雾变化情况。并用数码设备摄像记录测试情况。
13、臭氧浓度检测
 (1)关闭空调送风系统,并关闭新风和直排风。
(1)关闭空调送风系统,并关闭新风和直排风。
(2)在静态情况下,开启臭氧发生器,将臭氧分析仪放置在被测房间内,开启仪器待系统平衡后离开房间,并记录开启时间。经过一定时间后,检测员进入被测房间观察臭氧浓度,待浓度达到合格浓度时,记录时间。
(3)验证合格浓度保持时间:在被测房间监测一定时间,记录浓度。并观察其浓度是否会降至合格浓度以下。
(4)验证消退浓度时间:全部房间验证结束后,关闭臭氧发生器,打开新风和直排风,记录房间臭氧浓度降至安全浓度时所需时间,关闭仪器电源离开房间。
14、高效过滤器检漏
 (1)气溶胶烟雾的引入
(1)气溶胶烟雾的引入
a.系统检漏可直接把气溶胶发生器放入空调器内进行发烟。
b.对于层流罩、超净台和生物安全柜上的高效过滤器,可直接把气溶胶烟雾从系统风机的负压一侧(风机吸入口)引入。
 (2)气溶胶光度计初始化
(2)气溶胶光度计初始化
a.初始化之后,设备将自动建立零点。
b.设置上游100%浓度”,过滤器上风侧发放的浓度一般为20~30ug/L即可。
(3)检测操作
 a.上游100%浓度成功设置之后,就可以进行按“上一次的100%设定”选项执行泄露测试。对被检过滤器整个断面、封胶头和安装框架间进行扫描。扫描时速度约2cm/s,采样探头距过滤器出风面和框架结构约3cm。
a.上游100%浓度成功设置之后,就可以进行按“上一次的100%设定”选项执行泄露测试。对被检过滤器整个断面、封胶头和安装框架间进行扫描。扫描时速度约2cm/s,采样探头距过滤器出风面和框架结构约3cm。
b.扫描检漏过程中,为了确认上风向气溶胶浓度的稳定,应以适当时间间隔复测上风气溶胶浓度,一般测完10个过滤器后复测一次。
c.扫描时任何等于或大于已指定限值的迹象时,都应将扫描探头在相应位置持续相当时间,凭借该位置较长时间内显示的最大值做出判断。
d.原始记录上画出示意图,标明泄漏位置和最大泄漏值。
15、细菌菌落总数
a.空气中细菌菌落总数
a.空气中细菌菌落总数
在动态下进行。采样时,将含营养琼脂培养基的平板置采样点(约桌面高度),打开平皿盖,使平板在空气中暴露一定时间,送检培养。
b.工作台表面细菌菌落总数
将经灭菌规格板放在被检物体表面,用一浸有灭菌生理盐水的棉签在其内来回涂抹,然后剪去手接触部分棉棒,将棉签放入灭菌生理盐水的采样管内送检。
c.工人手表面细菌菌落总数
被检人五指并拢,用一浸湿生理盐水的棉签在右手指曲面,从指尖到指端来回涂擦,然后剪去手接触部分棉签,将棉签放入灭菌生理盐水的采样管内送检。
16、紫外强度
 紫外线光强度照度计测定法:开启紫外线灯5min后,将紫外辐照计探头置于被检紫外线灯下垂直距离1m的中央处,待仪表稳定后,所示数据即为该紫外线灯管的辐照度值。
紫外线光强度照度计测定法:开启紫外线灯5min后,将紫外辐照计探头置于被检紫外线灯下垂直距离1m的中央处,待仪表稳定后,所示数据即为该紫外线灯管的辐照度值。
17、静电检测
 在表面上人活动区域选定的一组2点间或几组2点间检测,将仪表的两根测试线分别置于EARTH与LINE两端,两个测夹分别于两个标准电极连接,将标准电极置于被测物体的表面上,待仪表稳定后读数,得出两点之间的电阻值。
在表面上人活动区域选定的一组2点间或几组2点间检测,将仪表的两根测试线分别置于EARTH与LINE两端,两个测夹分别于两个标准电极连接,将标准电极置于被测物体的表面上,待仪表稳定后读数,得出两点之间的电阻值。